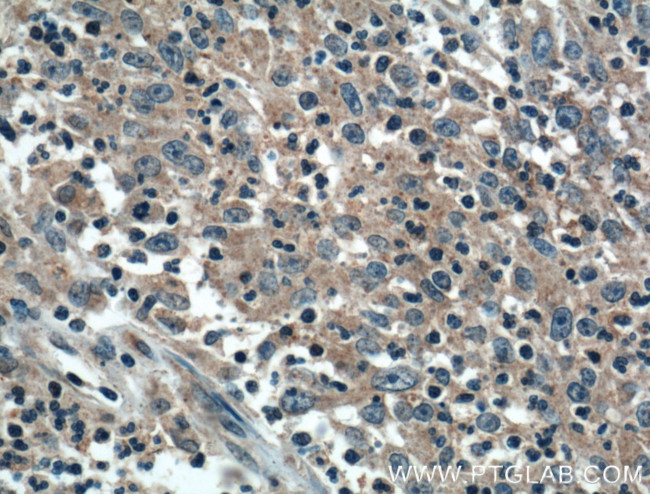
ADHFE1 Antibody in Immunohistochemistry (Paraffin) (IHC (P))
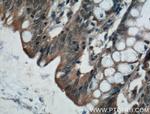
ADHFE1 Antibody in Immunohistochemistry (Paraffin) (IHC (P))
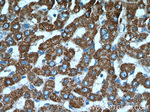
ADHFE1 Antibody in Immunohistochemistry (Paraffin) (IHC (P))

Search
Proteintech
ADHFE1 Polyclonal Antibody
{{$productOrderCtrl.translations['antibody.pdp.commerceCard.promotion.promotions']}}
{{$productOrderCtrl.translations['antibody.pdp.commerceCard.promotion.viewpromo']}}
{{$productOrderCtrl.translations['antibody.pdp.commerceCard.promotion.promocode']}}: {{promo.promoCode}} {{promo.promoTitle}} {{promo.promoDescription}}. {{$productOrderCtrl.translations['antibody.pdp.commerceCard.promotion.learnmore']}}
产品信息
14674-1-AP
种属反应
宿主/亚型
分类
类型
抗原
偶联物
形式
浓度
规格
纯化类型
保存液
内含物
保存条件
运输条件
产品详细信息
Immunogen sequence: MAVSNIRYG AAVTKEVGMD LKNMGAKNVC LMTDKNLSKL PPVQVAMDSL VKNGIPFTVY DNVRVEPTDS SFMEAIEFAQ KGAFDAYVAV GGGSTMDTCK AANLYASSPH SDFLDYVSAP IGKGKPVSVP LKPLIAVPTT SGTGSETTGV AIFDYEHLKV KIGITSRAIK PTLGLIDPLH TLHMPARVVA NSGFDVLCHA LESYTTLPYH LRSPCPSNPI TRPAYQGSNP ISDIWAIHAL RIVAKYLKRA VNSTDK (1-255 aa encoded by B C064634)
靶标信息
The ADHFE1 gene encodes hydroxyacid-oxoacid transhydrogenase (EC 1.1.99.24), which is responsible for the oxidation of 4-hydroxybutyrate in mammalian tissues (Kardon et al., 2006 ).
仅用于科研。不用于诊断过程。未经明确授权不得转售。
生物信息学
蛋白别名: ADH8; ADHFe1; alcohol dehydrogenase 8; Alcohol dehydrogenase iron-containing protein 1; Fe-containing alcohol dehydrogenase; Fe-containing alcohol dehydrogenase 1; HOT; Hydroxyacid-oxoacid transhydrogenase, mitochondrial; unnamed protein product
基因别名: 6330565B14Rik; ADH8; ADHFE1; AI043035; HMFT2263; HOT
UniProt ID: (Human) Q8IWW8, (Mouse) Q78SV3, (Rat) Q4QQW3
Entrez Gene ID: (Human) 137872, (Mouse) 76187, (Rat) 362474